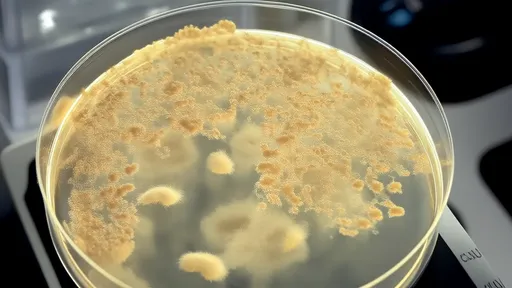

The world of fitness is constantly evolving, with new trends emerging from every corner of the globe. While some workouts stand the test of time, others are so peculiar they make you wonder - who thought this was a good idea? From goat yoga to face slapping workouts, humanity's quest for better health has spawned some truly unconventional practices that blur the line between genius and madness.
The fitness world is buzzing with excitement over the latest viral workout trend—Divine Beats Training 2.0. This high-energy program combines pulsating electronic dance music with scientifically optimized movement patterns, creating what enthusiasts call "the first workout that feels like a nightclub experience." Unlike traditional exercise routines, this system uses precisely timed musical drops and bass-heavy beats to trigger explosive physical responses from participants.
The growing popularity of energy drinks has sparked significant interest in their physiological effects, particularly on cardiovascular health. Recent studies utilizing electrocardiogram (ECG) monitoring have begun to unravel the complex relationship between these caffeine-laden beverages and heart function. As millions worldwide consume energy drinks for a quick boost, researchers are investigating whether these products may trigger subtle yet meaningful changes in cardiac rhythm.
Walking is often touted as one of the simplest and most effective forms of exercise, accessible to almost everyone regardless of fitness level. However, as the trend of hitting extreme step counts—such as 30,000 steps a day—gains popularity, concerns about joint wear and tear have emerged. While moderate walking is beneficial, pushing the body to such extremes may come at a cost, particularly for the knees, hips, and ankles. This raises an important question: how much is too much when it comes to daily steps?
The crisp morning air, the quiet streets, and the promise of a fresh start make dawn an irresistible time for runners. Yet beneath the serenity of sunrise jogs lies a hidden danger few anticipate – exercise-induced syncope, particularly when running in a fasted state. This phenomenon isn’t merely about "feeling lightheaded"; it’s a temporary loss of consciousness that can lead to catastrophic falls or accidents. As more people adopt fasting routines or squeeze workouts before breakfast, understanding why this happens and how to respond could mean the difference between a close call and a tragedy.
Ligamentous laxity caused by overstretching is a complex clinical condition that often requires advanced imaging for accurate diagnosis. Magnetic resonance imaging (MRI) has emerged as the gold standard for evaluating ligament integrity, providing unparalleled soft tissue contrast that allows clinicians to assess the degree of ligament injury and subsequent laxity. This imaging modality reveals not only the macroscopic tears but also subtle microstructural changes that occur when ligaments are stretched beyond their physiological limits.
For decades, the idea of converting fat into muscle—or vice versa—has been a topic of fascination in fitness and medical communities. While the concept is often oversimplified in popular media, the biological mechanisms behind this transformation are complex and deeply rooted in cellular metabolism. Understanding how the body regulates the interplay between adipose tissue and muscle mass requires delving into the biochemical pathways that govern energy storage and utilization.
The medical community has long grappled with the complexities of localized cryogenic burns, a unique injury pattern that occurs when skin and underlying tissues are exposed to extreme cold. Unlike thermal burns which follow more predictable pathways, cryogenic injuries present distinct clinical challenges due to their delayed presentation and progressive tissue damage. Recent multicenter studies have shed new light on the pathophysiology and optimal treatment approaches for these frostbite-like injuries caused by industrial accidents, medical cryotherapy mishaps, and improper handling of liquefied gases.
The medical community has long been fascinated by the intricate relationship between skeletal deformities and their underlying causes. Among these, costal arch deformities, particularly those involving the lower ribs, present a unique challenge for both diagnosis and treatment. Often referred to as "corset rib syndrome" or "lower rib cage deformity," this condition manifests as an abnormal inward curvature of the lower ribs, frequently accompanied by chronic pain and respiratory limitations. The condition's nomenclature stems from its historical association with tight-lacing corsets, though modern cases often arise from congenital factors or trauma.
Pulse oximeters have become indispensable tools in modern healthcare, particularly in monitoring oxygen saturation levels non-invasively. However, one common challenge users face is nail interference, which can skew readings and lead to inaccurate results. Understanding how to mitigate this issue is crucial for both medical professionals and individuals relying on these devices for health monitoring.
The pharmaceutical industry has undergone significant transformations in recent years, with one of the most notable advancements being the implementation of drug traceability systems. These systems, often centered around unique identification codes known as drug traceability codes, have become a cornerstone in ensuring the safety, authenticity, and transparency of pharmaceutical products. The ability to track a drug's journey from manufacturing to consumption has not only bolstered consumer confidence but also streamlined regulatory compliance and supply chain management.
The rise of digital healthcare credentials has brought unprecedented convenience to patients worldwide, but it has also opened new avenues for fraudsters. Electronic medical insurance certificates, designed to streamline access to healthcare services, have become a prime target for sophisticated cybercriminals. This phenomenon isn't isolated to any particular region—from Beijing to Boston, healthcare systems are witnessing an alarming increase in digital credential theft.
The rise of telemedicine has transformed how patients access healthcare, with online consultations becoming increasingly common. One critical aspect of virtual visits that often goes overlooked is the quality of medical photos patients submit. Clear, well-composed images can make the difference between an accurate remote diagnosis and unnecessary follow-up appointments. As patients take more responsibility for documenting their health concerns through photography, mastering a few fundamental techniques becomes essential.
The growing reliance on health apps has brought privacy and security concerns to the forefront. As these applications collect sensitive data—ranging from heart rate and sleep patterns to medical history and GPS locations—users and regulators alike are questioning how this information is managed. The permissions granted to health apps often determine the extent of data access, making it crucial to establish robust strategies for permission management.
In today’s fast-paced world, many of us find ourselves glued to our desks for hours on end, often losing track of time until stiffness or discomfort sets in. Sedentary behavior has become a silent health hazard, linked to a range of issues from poor posture to increased risk of chronic diseases. Fortunately, wearable technology like fitness bands has stepped in to combat this modern-day problem. One of the most valuable features these devices offer is the sedentary reminder—a gentle nudge to get up and move. But simply enabling the feature isn’t enough; understanding how to optimize its settings can make the difference between a helpful tool and an ignored alert.
The modern pace of life has made fast food an unavoidable part of our dietary landscape. While nutritionists consistently warn about the health consequences of regular fast food consumption, the reality is that most people will find themselves eating these convenient meals more often than they'd like to admit. Rather than moralizing about avoidance, a more practical approach focuses on mitigation - how to nutritionally rescue your body after fast food consumption.
In our screen-dominated world, eye fatigue has become an epidemic. The constant glare from digital devices leaves millions rubbing their temples and squinting through blurred vision. While artificial tears and blue light glasses offer temporary relief, traditional Chinese medicine presents an intriguing alternative – acupressure for eye strain. This ancient healing art teaches that strategic finger pressure along meridian pathways can dissolve tension, improve circulation, and restore visual clarity without medications.
Air-conditioned rooms provide comfort during hot weather, but they often come with an unintended side effect: dry nasal passages. The constant circulation of cooled air tends to strip moisture from the environment, leaving many people struggling with irritation, congestion, or even nosebleeds. Understanding how to maintain nasal hydration in such conditions is essential for both comfort and health.
For those who spend long hours sitting at a desk or in front of a computer, the struggle with stiff calves and poor circulation is all too real. The modern sedentary lifestyle has given rise to a generation of "desk-bound professionals" who often neglect the importance of movement. Enter the calf massage roller—a simple yet effective tool designed to alleviate tension, improve blood flow, and restore mobility to overworked lower legs.
In today's fast-paced corporate environment, telephone conferences have become an indispensable part of daily work routines. However, the prolonged hours spent hunched over phones or laptops during these virtual meetings have given rise to a silent epidemic: chronic neck and shoulder pain. As awareness grows about the physical toll of our digital work habits, a new category of ergonomic solutions has emerged – the telephone conference neck support brace.
Business travel often comes with its own set of challenges, and one of the most overlooked yet critical aspects is the quality of sleep. Hotels, aware of this, have started paying closer attention to their pillow offerings. The way hotels handle pillows can significantly impact a guest's experience, and many are now adopting innovative approaches to ensure comfort and hygiene.
Afternoon tea is a beloved ritual for many, offering a moment of respite in the midst of a busy day. However, traditional afternoon tea spreads often lean heavily on sugary treats, refined carbohydrates, and calorie-laden snacks. For those seeking a healthier approach without sacrificing flavor or satisfaction, there are plenty of nutritious alternatives that can transform this daily indulgence into a nourishing experience.
The modern workplace can be a breeding ground for stress, and often, the state of our physical surroundings mirrors our mental clutter. Nowhere is this more evident than in the humble desk drawer—a microcosm of chaos for many professionals. The concept of drawer decompression organizing isn’t just about tidying up; it’s a tactile form of self-care that bridges the gap between productivity and mental well-being.
In today’s fast-paced digital world, keyboards have become an essential part of our daily lives. Whether at work, school, or home, we rely on them for communication, productivity, and entertainment. However, what many people overlook is the fact that keyboards can harbor a surprising amount of germs and bacteria. Studies have shown that keyboards can be dirtier than toilet seats, making regular cleaning a necessity. One effective and convenient solution for maintaining keyboard hygiene is the use of disinfecting wipes. These wipes are specially designed to clean and sanitize surfaces without causing damage, making them ideal for electronic devices.
The art of baking a perfect cake relies heavily on understanding the science behind its structure. Among the many factors that contribute to a cake's texture, the uniformity of air pockets within the cake crumb stands out as a critical element. This characteristic is largely influenced by the foaming properties of proteins in the batter, particularly those found in eggs. The way proteins trap and stabilize air bubbles during mixing directly impacts the final product's lightness, tenderness, and overall mouthfeel.
The world of sensory evaluation is as intricate as it is fascinating, particularly when it comes to understanding how we perceive flavors and aromas. Among the myriad of compounds that contribute to our sensory experiences, vanillin—the primary component of vanilla extract—stands out for its widespread use and complex interaction with our senses. The concept of odor threshold plays a pivotal role in determining how much of this compound is needed for it to be detectable, and it varies significantly depending on the medium in which it is presented.
The world of chili peppers is as diverse as it is fiery, with each variety packing its own unique punch. At the heart of understanding this heat lies the Scoville Scale, a measurement that quantifies the spiciness of peppers. Developed by Wilbur Scoville in 1912, this scale remains the gold standard for gauging the capsaicin content—the compound responsible for that burning sensation—in different peppers. From the mild bell pepper to the mind-numbing Carolina Reaper, the Scoville Scale offers a fascinating glimpse into the spectrum of heat that chili enthusiasts chase.
The culinary world has long celebrated the magic that happens when certain ingredients come together, creating flavors greater than the sum of their parts. One such pairing—chicken broth and mushrooms—exemplifies the scientific and gastronomic phenomenon known as umami synergy. This dynamic duo has been a staple in kitchens across cultures, from French consommé to Japanese ramen, and its power lies in the way their compounds interact to amplify savory depth.
The world of fermented foods is a fascinating intersection of microbiology, chemistry, and culinary tradition. Among these, kimchi stands out not only for its bold flavors but also for the intricate biochemical processes that transform raw vegetables into a probiotic-rich delicacy. At the heart of this transformation lies a phenomenon known as acetic acid penetration, which creates a dynamic pH gradient during fermentation. This process is far more than a simple souring of cabbage—it's a carefully orchestrated dance between microbial communities and their chemical environment.
The turbidity of fruit juice, often perceived as a mark of freshness and natural quality, is primarily governed by the suspension mechanisms of pulp particles. These tiny fragments of fruit flesh, ranging from cellular debris to larger fibrous clusters, create the characteristic cloudiness that consumers associate with premium products. Behind this seemingly simple phenomenon lies a complex interplay of physical forces, biochemical interactions, and processing variables that determine whether pulp remains evenly dispersed or separates over time.
The fizz in your soda isn't just about taste—it's a carefully engineered dance between gas and liquid that begins unraveling the moment you twist open the cap. Few consumers realize how precisely carbonation levels are calibrated, or how dramatically pressure dynamics shift during that first explosive release. This invisible physics experiment in every bottle follows predictable but fascinating patterns that beverage scientists have spent decades mapping.
The world of espresso is as complex as it is captivating, with its rich flavors and aromatic allure. At the heart of this complexity lies a seemingly simple yet scientifically intricate component: the crema. This golden-brown layer of foam that crowns a well-pulled shot of espresso is not just a visual delight but a fascinating study in colloidal stability. The interplay of oils, gases, and solids in espresso crema reveals a delicate balance that defines the quality and texture of the coffee.
The phenomenon of "cold turbidity" or "cream down" in tea has long intrigued both tea connoisseurs and scientists alike. This natural occurrence, where tea liquor turns cloudy upon cooling, is not merely an aesthetic curiosity but a window into the complex chemistry of tea. Recent advancements in optical measurement techniques have enabled researchers to quantify this phenomenon through turbidity detection based on tea liquor transmittance, opening new avenues for quality assessment and understanding of tea's molecular interactions.
The world of instant noodles thrives on convenience, but behind that simplicity lies a carefully engineered marvel of food science. At the heart of this innovation sits pregelatinized starch—an unsung hero that transforms dehydrated noodles into a steaming bowl of comfort within minutes. Unlike traditional starch, pregelatinized starch undergoes a thermal and mechanical treatment that breaks down its granular structure, allowing it to absorb water rapidly. This property is pivotal for instant noodles, where rehydration speed and texture determine consumer satisfaction.
The world of traditional fermented foods holds countless microbial secrets, and few are as fascinating as the complex ecosystem of laomian – the centuries-old sourdough starter that gives Chinese steamed bread its distinctive character. While modern bakeries increasingly rely on commercial yeast, artisanal producers across northern China still maintain their family laomian cultures like precious heirlooms, passing down not just techniques but living microbial communities through generations.
The sticky, chewy texture of glutinous rice cakes, known as mochi in Japanese or nuòmǐ cí in Chinese, has long been a staple in East Asian cuisine. These delectable treats, often enjoyed during festivals or as everyday snacks, owe their unique consistency to a key component: amylopectin, the branched-chain starch found in glutinous rice. However, anyone who has left mochi or Chinese mochi cakes (糍粑) at room temperature for a few hours will notice an unmistakable transformation—the once-soft and pliable dessert gradually hardens, becoming tougher and less enjoyable. This phenomenon, often referred to as retrogradation, is a fascinating interplay of chemistry, physics, and culinary science.
The art of cooking perfect rice lies in understanding the gelatinization temperature of different japonica rice varieties. This scientific parameter, often overlooked by home cooks, determines the precise moment when starch granules absorb water and swell—fundamentally shaping texture, flavor release, and nutritional accessibility. Recent studies across Asian research institutions reveal how subtle genetic variations in short-grain rice cultivars create distinct thermal behaviors during cooking, challenging the one-size-fits-all approach to water ratios and heat application.
The art of crafting perfect hand-pulled noodles lies in mastering the delicate balance between gluten development and dough relaxation. Among the many variables that influence noodle extensibility, resting time stands as one of the most critical yet often overlooked factors. This silent alchemy occurring during the waiting period transforms a stiff, unyielding mass into an elastic, cooperative material ready to be stretched into silky strands.
For generations, home cooks and professional chefs alike have relied on stainless steel containers for pickling and food storage. The material's reputation for durability and corrosion resistance makes it a seemingly ideal choice. But when acidic ingredients like vinegar enter the equation, questions arise about potential metal leaching and food safety. Understanding the interaction between stainless steel and pickling brines requires a deeper dive into metallurgy, chemistry, and culinary science.
The bamboo steamer, a centuries-old culinary tool cherished across Asian kitchens, operates on principles far more sophisticated than its simple appearance suggests. Among its most fascinating phenomena is the so-called "bamboo steamer effect" – a self-regulating mechanism that prevents the dreaded condensation drip-back, ensuring perfectly textured dumplings, buns, and fish every time. This natural engineering marvel has captivated chefs and scientists alike, revealing how traditional wisdom often anticipates modern food science.
The age-old practice of stone milling has long been revered for its ability to produce flour that retains the natural goodness of whole grains. Unlike modern industrial milling methods, which often prioritize speed and shelf life, stone grinding operates at a slower pace, preserving the integrity of the grain’s nutritional profile. One of the most significant advantages of this traditional method is its ability to maintain higher levels of dietary fiber in whole wheat flour—a component essential for digestive health, blood sugar regulation, and overall well-being.
 Fitness
Fitness
 Fitness
Fitness
 Fitness
Fitness
 Fitness
Fitness
 Fitness
Fitness
 Fitness
Fitness
 Fitness
Fitness
 Fitness
Fitness












 TOP
TOP
 TOP
TOP
 TOP
TOP
 TOP
TOP
 TOP
TOP
 TOP
TOP
 TOP
TOP
 TOP
TOP
 TOP
TOP
 TOP
TOP
 TOP
TOP
 TOP
TOP
 TOP
TOP
 TOP
TOP
 TOP
TOP
 TOP
TOP
 TOP
TOP
 TOP
TOP
 TOP
TOP
 TOP
TOP
TOP
TOP
 TOP
TOP
 TOP
TOP
 TOP
TOP
 TOP
TOP
 TOP
TOP
 TOP
TOP